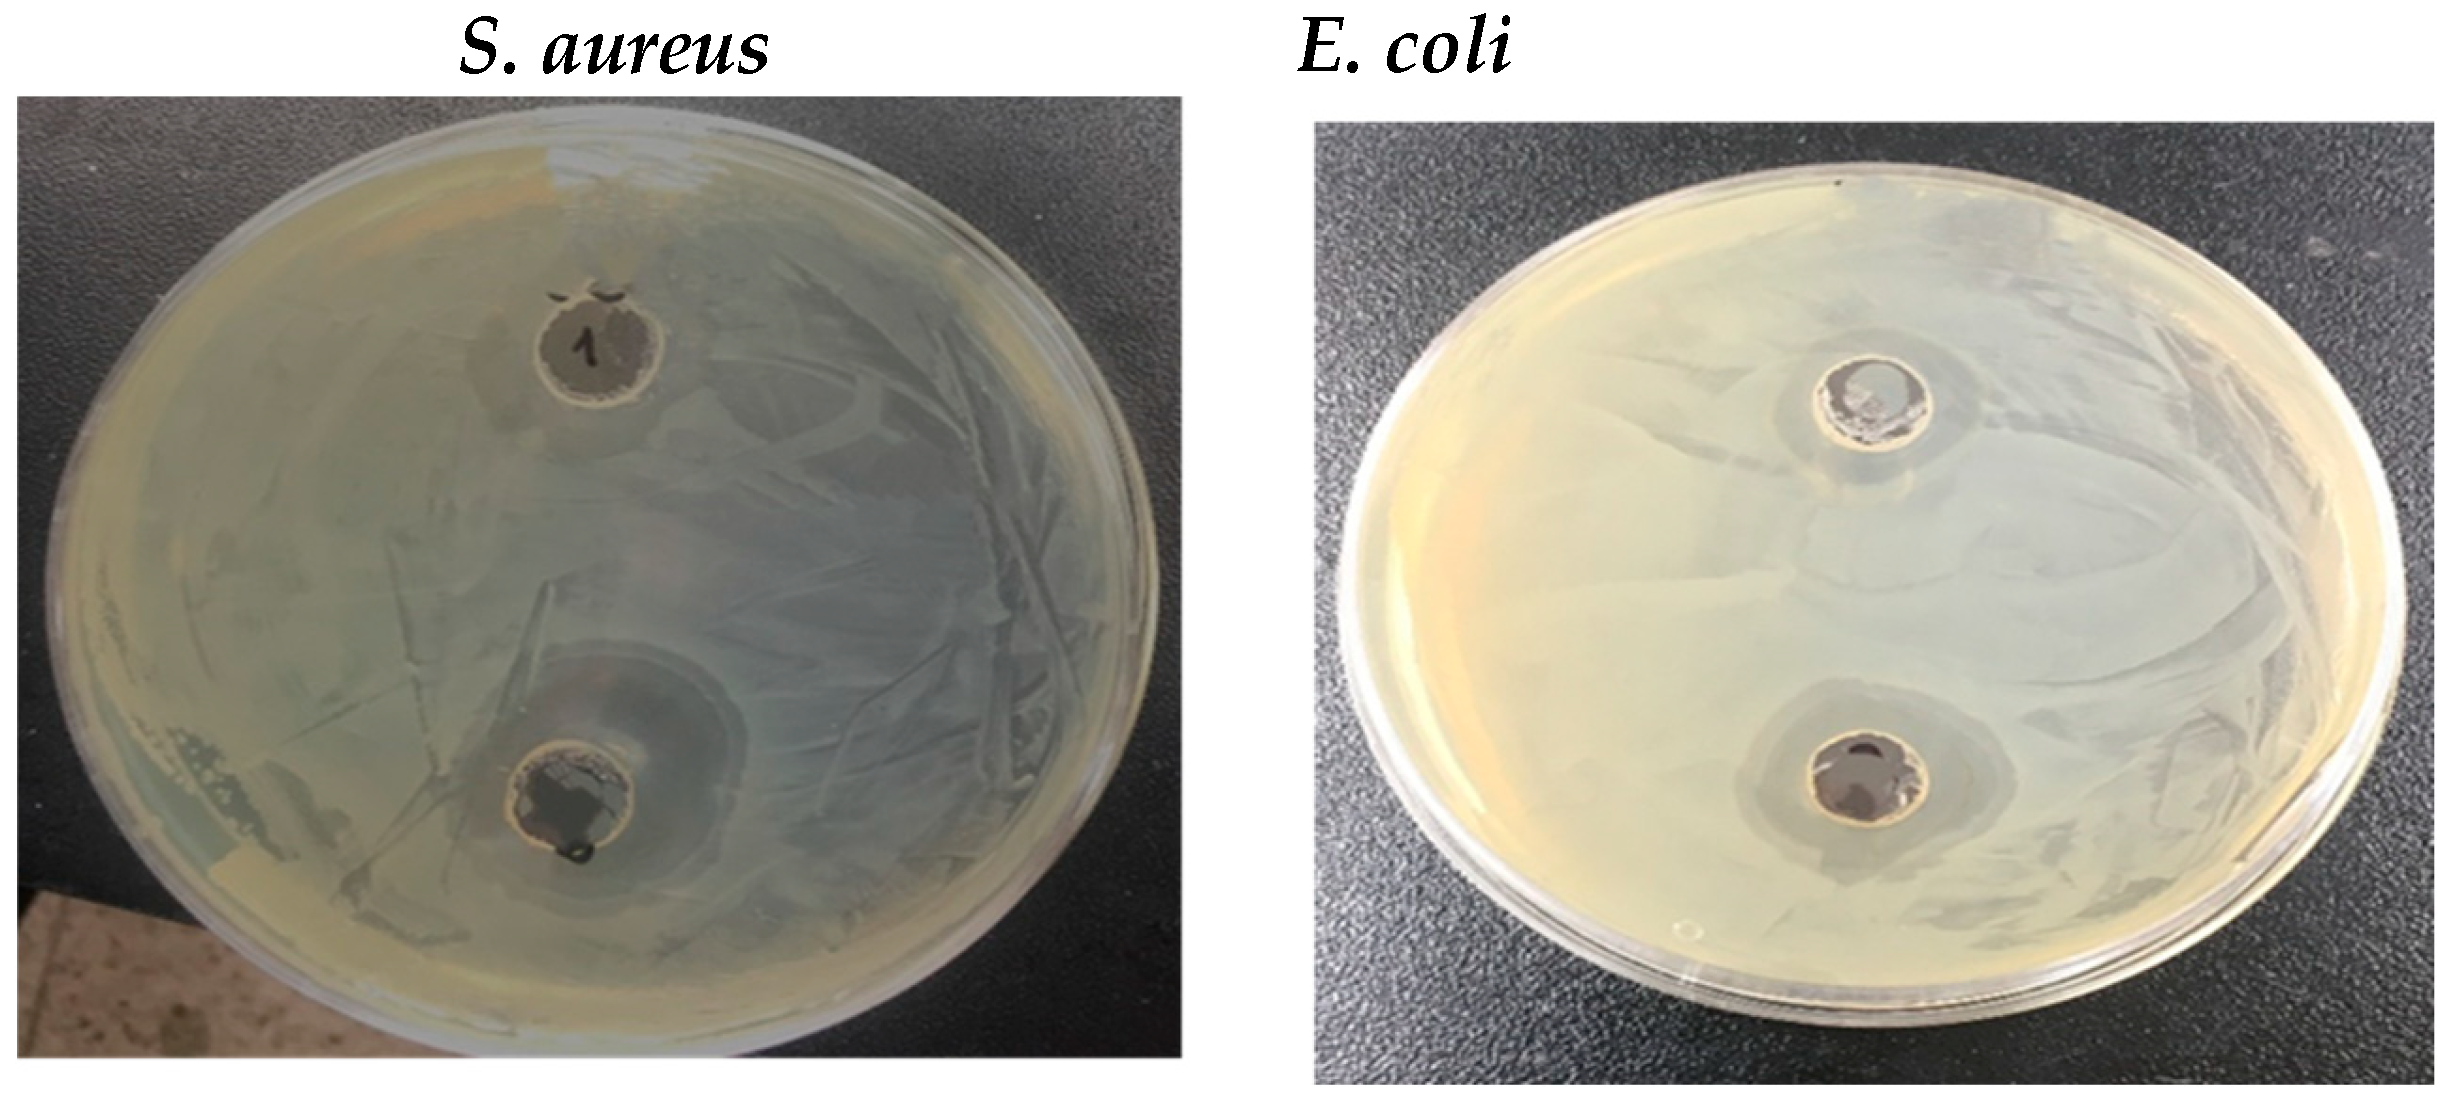
Nanomaterials 14 01339 g007

Green Synthesis of Cobalt-Doped CeFe2O5 Nanocomposites Using Waste Gossypium arboreum L. Stalks and Their Application in the Removal of Toxic Water Pollutants
Abstract
1. Introduction
2. Materials and Methods
2.1. Materials
2.2. Synthesis of Cobalt-Doped Cerium Iron Oxide Nanocomposites (CCIO NCs)
2.3. Characterization of Synthesized CCIO NCs
2.4. Preparation of Cationic Dyes
2.5. Preparation of Hexavalent Chromium Solution
2.6. Adsorption Analysis
2.7. Antioxidant Activity
2.8. Antimicrobial Activity
2.9. Recycling and Reuse of Used CCIO NCs
3. Results and Discussion
3.1. Synthesis and Characterization of the Synthesized CCIO NCs
3.2. Adsorption Studies
3.2.1. Adsorption Performance of CCIO NCs for Cationic Dye Removal
3.2.2. Adsorption Performance of CCIO NCs for Chromium Removal
3.2.3. Comparative Analysis
3.3. Radical Scavenging Activity
3.4. Antimicrobial Activity
3.5. Reusability of CCIO NCs
3.6. Plausible Mechanism of Dye Removal Due to the Action of CCIO NCs
4. Conclusions
Supplementary Materials
Author Contributions
Funding
Institutional Review Board Statement
Data Availability Statement
Acknowledgments
Conflicts of Interest
References
- Loux, N.T.; Su, Y.S.; Hassan, S.M. Issues in Assessing Environmental Exposures to Manufactured Nanomaterials. Int. J. Environ. Res. Public Health 2011, 8, 3562–3578. [Google Scholar] [CrossRef]
- Balali-Mood, M.; Naseri, K.; Tahergorabi, Z.; Khazdair, M.R.; Sadeghi, M. Toxic Mechanisms of Five Heavy Metals: Mercury, Lead, Chromium, Cadmium, and Arsenic. Front. Pharmacol. 2021, 12, 643972. [Google Scholar] [CrossRef]
- Wani, K.A.; Jangid, N.K.; Bhat, A.R. (Eds.) Impact of Textile Dyes on Public Health and the Environment; IGI Global: Hershey, PA, USA, 2019; ISBN 978-1-79980-313-3. [Google Scholar]
- Mudgal, V.; Madaan, N.; Mudgal, A.; Singh, R.B.; Mishra, S. Effect of Toxic Metals on Human Health. Open Nutraceuticals J. 2010, 3, 94–99. [Google Scholar] [CrossRef]
- Anastopoulos, I.; Hosseini-Bandegharaei, A.; Fu, J.; Mitropoulos, A.C.; Kyzas, G.Z. Use of Nanoparticles for Dye Adsorption: Review. J. Dispers. Sci. Technol. 2018, 39, 836–847. [Google Scholar] [CrossRef]
- Baig, N.; Kammakakam, I.; Falath, W. Nanomaterials: A Review of Synthesis Methods, Properties, Recent Progress, and Challenges. Mater. Adv. 2021, 2, 1821–1871. [Google Scholar] [CrossRef]
- Hlongwane, G.N.; Sekoai, P.T.; Meyyappan, M.; Moothi, K. Simultaneous Removal of Pollutants from Water Using Nanoparticles: A Shift from Single Pollutant Control to Multiple Pollutant Control. Sci. Total Environ. 2019, 656, 808–833. [Google Scholar] [CrossRef] [PubMed]
- Hussain, I. Green Synthesis of Nanoparticles and Its Potential Application. Biotechnol. Lett. 2016, 38, 545–560. [Google Scholar] [CrossRef] [PubMed]
- Savage, N.; Diallo, M.S. Nanomaterials and Water Purification: Opportunities and Challenges. J. Nanopart Res. 2005, 7, 331–342. [Google Scholar] [CrossRef]
- Lee, C.S.; Robinson, J.; Chong, M.F. A Review on Application of Flocculants in Wastewater Treatment. Process Saf. Environ. Prot. 2014, 92, 489–508. [Google Scholar] [CrossRef]
- Leiknes, T. The Effect of Coupling Coagulation and Flocculation with Membrane Filtration in Water Treatment: A Review. J. Environ. Sci. 2009, 21, 8–12. [Google Scholar] [CrossRef]
- Wang, J.; Chen, H. Catalytic Ozonation for Water and Wastewater Treatment: Recent Advances and Perspective. Sci. Total Environ. 2020, 704, 135249. [Google Scholar] [CrossRef] [PubMed]
- Hube, S.; Eskafi, M.; Hrafnkelsdóttir, K.F.; Bjarnadóttir, B.; Bjarnadóttir, M.Á.; Axelsdóttir, S.; Wu, B. Direct Membrane Filtration for Wastewater Treatment and Resource Recovery: A Review. Sci. Total Environ. 2020, 710, 136375. [Google Scholar] [CrossRef] [PubMed]
- Perrich, J.R. Activated Carbon Adsorption for Wastewater Treatment; CRC Press: Boca Raton, FL, USA, 2018; ISBN 978-1-351-07791-0. [Google Scholar]
- Shahedi, A.; Darban, A.K.; Taghipour, F.; Jamshidi-Zanjani, A. A Review on Industrial Wastewater Treatment via Electrocoagulation Processes. Curr. Opin. Electrochem. 2020, 22, 154–169. [Google Scholar] [CrossRef]
- Butler, E.; Hung, Y.-T.; Yeh, R.Y.-L.; Suleiman Al Ahmad, M. Electrocoagulation in Wastewater Treatment. Water 2011, 3, 495–525. [Google Scholar] [CrossRef]
- Rashid, R.; Shafiq, I.; Akhter, P.; Iqbal, M.J.; Hussain, M. A State-of-the-Art Review on Wastewater Treatment Techniques: The Effectiveness of Adsorption Method. Environ. Sci. Pollut. Res. 2021, 28, 9050–9066. [Google Scholar] [CrossRef]
- Rajendran, S.; Priya, A.K.; Senthil Kumar, P.; Hoang, T.K.A.; Sekar, K.; Chong, K.Y.; Khoo, K.S.; Ng, H.S.; Show, P.L. A Critical and Recent Developments on Adsorption Technique for Removal of Heavy Metals from Wastewater-A Review. Chemosphere 2022, 303, 135146. [Google Scholar] [CrossRef] [PubMed]
- Brahmi, M.; Hassen, A. Ultraviolet Radiation for Microorganism Inactivation in Wastewater. J. Environ. Prot. 2012, 2012. [Google Scholar] [CrossRef]
- Oller, I.; Malato, S.; Sánchez-Pérez, J.A. Combination of Advanced Oxidation Processes and Biological Treatments for Wastewater Decontamination—A Review. Sci. Total Environ. 2011, 409, 4141–4166. [Google Scholar] [CrossRef] [PubMed]
- Prasse, C.; Ternes, T. Removal of Organic and Inorganic Pollutants and Pathogens from Wastewater and Drinking Water Using Nanoparticles—A Review. In Nanoparticles in the Water Cycle: Properties, Analysis and Environmental Relevance; Frimmel, F.H., Niessner, R., Eds.; Springer: Berlin/Heidelberg, Germany, 2010; pp. 55–79. ISBN 978-3-642-10318-6. [Google Scholar]
- Aragaw, T.A.; Bogale, F.M.; Aragaw, B.A. Iron-Based Nanoparticles in Wastewater Treatment: A Review on Synthesis Methods, Applications, and Removal Mechanisms. J. Saudi Chem. Soc. 2021, 25, 101280. [Google Scholar] [CrossRef]
- Mondal, P.; Nandan, A.; Ajithkumar, S.; Siddiqui, N.A.; Raja, S.; Kola, A.K.; Balakrishnan, D. Sustainable Application of Nanoparticles in Wastewater Treatment: Fate, Current Trend & Paradigm Shift. Environ. Res. 2023, 232, 116071. [Google Scholar] [CrossRef]
- Theerthagiri, J.; Lee, S.J.; Karuppasamy, K.; Park, J.; Yu, Y.; Kumari, M.L.A.; Chandrasekaran, S.; Kim, H.-S.; Choi, M.Y. Fabrication Strategies and Surface Tuning of Hierarchical Gold Nanostructures for Electrochemical Detection and Removal of Toxic Pollutants. J. Hazard. Mater. 2021, 420, 126648. [Google Scholar] [CrossRef] [PubMed]
- Singh, J.; Kumar, V.; Singh Jolly, S.; Kim, K.-H.; Rawat, M.; Kukkar, D.; Tsang, Y.F. Biogenic Synthesis of Silver Nanoparticles and Its Photocatalytic Applications for Removal of Organic Pollutants in Water. J. Ind. Eng. Chem. 2019, 80, 247–257. [Google Scholar] [CrossRef]
- Melkamu, W.W.; Bitew, L.T. Green Synthesis of Silver Nanoparticles Using Hagenia Abyssinica (Bruce) J.F. Gmel Plant Leaf Extract and Their Antibacterial and Anti-Oxidant Activities. Heliyon 2021, 7, e08459. [Google Scholar] [CrossRef] [PubMed]
- Gopinath, K.P.; Madhav, N.V.; Krishnan, A.; Malolan, R.; Rangarajan, G. Present Applications of Titanium Dioxide for the Photocatalytic Removal of Pollutants from Water: A Review. J. Environ. Manag. 2020, 270, 110906. [Google Scholar] [CrossRef] [PubMed]
- A Novel and Facile Green Synthesis of SiO2 Nanoparticles for Removal of Toxic Water Pollutants|Applied Nanoscience. Available online: https://link.springer.com/article/10.1007/s13204-021-01898-1 (accessed on 29 December 2023).
- Jadhav, S.A.; Garud, H.B.; Patil, A.H.; Patil, G.D.; Patil, C.R.; Dongale, T.D.; Patil, P.S. Recent Advancements in Silica Nanoparticles Based Technologies for Removal of Dyes from Water. Colloid Interface Sci. Commun. 2019, 30, 100181. [Google Scholar] [CrossRef]
- Bhateria, R.; Singh, R. A Review on Nanotechnological Application of Magnetic Iron Oxides for Heavy Metal Removal. J. Water Process Eng. 2019, 31, 100845. [Google Scholar] [CrossRef]
- Wang, J.; Zhang, J.; Han, L.; Wang, J.; Zhu, L.; Zeng, H. Graphene-Based Materials for Adsorptive Removal of Pollutants from Water and Underlying Interaction Mechanism. Adv. Colloid Interface Sci. 2021, 289, 102360. [Google Scholar] [CrossRef]
- Yap, P.L.; Nine, M.J.; Hassan, K.; Tung, T.T.; Tran, D.N.H.; Losic, D. Graphene-Based Sorbents for Multipollutants Removal in Water: A Review of Recent Progress. Adv. Funct. Mater. 2021, 31, 2007356. [Google Scholar] [CrossRef]
- Sanjeev, N.O.; Valsan, A.E.; Zachariah, S.; Vasu, S.T. Synthesis of Zinc Oxide Nanoparticles from Azadirachta Indica Extract: A Sustainable and Cost-Effective Material for Wastewater Treatment. J. Hazard. Toxic Radioact. Waste 2023, 27, 04023027. [Google Scholar] [CrossRef]
- Shabani, N.; Javadi, A.; Jafarizadeh-Malmiri, H.; Mirzaie, H.; Sadeghi, J. Potential Application of Iron Oxide Nanoparticles Synthesized by Co-Precipitation Technology as a Coagulant for Water Treatment in Settling Tanks. Min. Metall. Explor. 2021, 38, 269–276. [Google Scholar] [CrossRef]
- Bashir, A.; Malik, L.A.; Ahad, S.; Manzoor, T.; Bhat, M.A.; Dar, G.N.; Pandith, A.H. Removal of Heavy Metal Ions from Aqueous System by Ion-Exchange and Biosorption Methods. Environ. Chem. Lett. 2019, 17, 729–754. [Google Scholar] [CrossRef]
- Ebrahimi, M.; Van der Bruggen, B.; Hosseini, S.M.; Askari, M.; Nemati, M. Improving Electrochemical Properties of Cation Exchange Membranes by Using Activated Carbon-Co-Chitosan Composite Nanoparticles in Water Deionization. Ionics 2019, 25, 1199–1214. [Google Scholar] [CrossRef]
- Hosseini, S.M.; Sohrabnejad, S.; Nabiyouni, G.; Jashni, E.; Van der Bruggen, B.; Ahmadi, A. Magnetic Cation Exchange Membrane Incorporated with Cobalt Ferrite Nanoparticles for Chromium Ions Removal via Electrodialysis. J. Membr. Sci. 2019, 583, 292–300. [Google Scholar] [CrossRef]
- Farahbakhsh, J.; Vatanpour, V.; Ganjali, M.R.; Saeb, M.R. 21-Magnetic Nanoparticles in Wastewater Treatment. In Magnetic Nanoparticle-Based Hybrid Materials; Ehrmann, A., Nguyen, T.A., Ahmadi, M., Farmani, A., Nguyen-Tri, P., Eds.; Woodhead Publishing Series in Electronic and Optical Materials; Woodhead Publishing: Sawston, UK, 2021; pp. 547–589. ISBN 978-0-12-823688-8. [Google Scholar]
- Naseem, T.; Durrani, T. The Role of Some Important Metal Oxide Nanoparticles for Wastewater and Antibacterial Applications: A Review. Environ. Chem. Ecotoxicol. 2021, 3, 59–75. [Google Scholar] [CrossRef]
- Jamzad, M. Green Synthesis of Iron Oxide Nanoparticles by the Aqueous Extract of Laurus nobilis L. Leaves and Evaluation of the Antimicrobial Activity|SpringerLink. Available online: https://link.springer.com/article/10.1007/s40097-020-00341-1 (accessed on 20 May 2023).
- Ying, S.; Guan, Z.; Ofoegbu, P.C.; Clubb, P.; Rico, C.; He, F.; Hong, J. Green Synthesis of Nanoparticles: Current Developments and Limitations. Environ. Technol. Innov. 2022, 26, 102336. [Google Scholar] [CrossRef]
- Mittal, A.K.; Chisti, Y.; Banerjee, U.C. Synthesis of Metallic Nanoparticles Using Plant Extracts. Biotechnol. Adv. 2013, 31, 346–356. [Google Scholar] [CrossRef] [PubMed]
- Manogar, P.; Esther Morvinyabesh, J.; Ramesh, P.; Dayana Jeyaleela, G.; Amalan, V.; Ajarem, J.S.; Allam, A.A.; Seong Khim, J.; Vijayakumar, N. Biosynthesis and Antimicrobial Activity of Aluminium Oxide Nanoparticles Using Lyngbya Majuscula Extract. Mater. Lett. 2022, 311, 131569. [Google Scholar] [CrossRef]
- Joudeh, N.; Linke, D. Nanoparticle Classification, Physicochemical Properties, Characterization, and Applications: A Comprehensive Review for Biologists. J. Nanobiotechnol. 2022, 20, 262. [Google Scholar] [CrossRef]
- Das, P.; Das, M.K. Chapter 4-Production and Physicochemical Characterization of Nanocosmeceuticals. In Nanocosmeceuticals; Das, M.K., Ed.; Academic Press: Cambridge, MA, USA, 2022; pp. 95–138. ISBN 978-0-323-91077-4. [Google Scholar]
- Petcharoen, K.; Sirivat, A. Synthesis and Characterization of Magnetite Nanoparticles via the Chemical Co-Precipitation Method. Mater. Sci. Eng. B 2012, 177, 421–427. [Google Scholar] [CrossRef]
- Ali, M. Qualitative Analyses of Thin Film-Based Materials Validating New Structures of Atoms. Mater. Today Commun. 2023, 36, 106552. [Google Scholar] [CrossRef]
- Kim, M.; Singhvi, M.S.; Kim, B.S. Eco-Friendly and Rapid One-Step Fermentable Sugar Production from Raw Lignocellulosic Biomass Using Enzyme Mimicking Nanomaterials: A Novel Cost-Effective Approach to Biofuel Production. Chem. Eng. J. 2023, 465, 142879. [Google Scholar] [CrossRef]
- Ghanbary, F.; Jafarnejad, E. Removal of Malachite Green from the Aqueous Solutions Using Polyimide Nanocomposite Containing Cerium Oxide as Adsorbent. Inorg. Nano-Met. Chem. 2017, 47, 1675–1681. [Google Scholar] [CrossRef]
- Tkaczyk, A.; Mitrowska, K.; Posyniak, A. Synthetic Organic Dyes as Contaminants of the Aquatic Environment and Their Implications for Ecosystems: A Review. Sci. Total Environ. 2020, 717, 137222. [Google Scholar] [CrossRef] [PubMed]
- Hammad, E.N.; Salem, S.S.; Mohamed, A.A.; El-Dougdoug, W. Environmental Impacts of Ecofriendly Iron Oxide Nanoparticles on Dyes Removal and Antibacterial Activity. Appl. Biochem. Biotechnol. 2022, 194, 6053–6067. [Google Scholar] [CrossRef] [PubMed]
- Behera, S.K.; Sahni, S.; Tiwari, G.; Rai, A.; Mahanty, B.; Vinati, A.; Rene, E.R.; Pugazhendhi, A. Removal of Chromium from Synthetic Wastewater Using Modified Maghemite Nanoparticles. Appl. Sci. 2020, 10, 3181. [Google Scholar] [CrossRef]
- Singh, N.; Riyajuddin, S.; Ghosh, K.; Mehta, S.K.; Dan, A. Chitosan-Graphene Oxide Hydrogels with Embedded Magnetic Iron Oxide Nanoparticles for Dye Removal. ACS Appl. Nano Mater. 2019, 2, 7379–7392. [Google Scholar] [CrossRef]
- Kedare, S.B.; Singh, R.P. Genesis and Development of DPPH Method of Antioxidant Assay. J. Food Sci. Technol. 2011, 48, 412–422. [Google Scholar] [CrossRef] [PubMed]
- Singhvi, M.S.; Deshmukh, A.R.; Kim, B.S. Cellulase Mimicking Nanomaterial-Assisted Cellulose Hydrolysis for Enhanced Bioethanol Fermentation: An Emerging Sustainable Approach. Green Chem. 2021, 23, 5064–5081. [Google Scholar] [CrossRef]
- Ning, J.; Shi, P.; Jiang, M.; Liu, C.; Jia, Z. Synthesis and Characterization of Cerium Oxide/Iron Oxide Nanocomposite and Its Surface Acid-Base Characteristics. J. Environ. Chem. Eng. 2021, 9, 105540. [Google Scholar] [CrossRef]
- IR Spectrum Table. Available online: https://www.sigmaaldrich.com/IN/en/technical-documents/technical-article/analytical-chemistry/photometry-and-reflectometry/ir-spectrum-table (accessed on 3 June 2023).
- Mourdikoudis, S.; Pallares, R.M.; Thanh, N.T. Characterization Techniques for Nanoparticles: Comparison and Complementarity upon Studying Nanoparticle Properties. Nanoscale 2018, 10, 12871–12934. [Google Scholar] [CrossRef]
- Thorat, M.N.; Dastager, S.G. High Yield Production of Cellulose by a Komagataeibacter Rhaeticus PG2 Strain Isolated from Pomegranate as a New Host. RSC Adv. 2018, 8, 29797–29805. [Google Scholar] [CrossRef]
- Azari, A.; Noorisepehr, M.; Dehghanifard, E.; Karimyan, K.; Hashemi, S.Y.; Kalhori, E.M.; Norouzi, R.; Agarwal, S.; Gupta, V.K. Experimental Design, Modeling and Mechanism of Cationic Dyes Biosorption on to Magnetic Chitosan-Lutaraldehyde Composite. Int. J. Biol. Macromol. 2019, 131, 633–645. [Google Scholar] [CrossRef]
- Rahmi; Ishmaturrahmi; Mustafa, I. Methylene Blue Removal from Water Using H2SO4 Crosslinked Magnetic Chitosan Nanocomposite Beads. Microchem. J. 2019, 144, 397–402. [Google Scholar] [CrossRef]
- Burakov, A.E.; Galunin, E.V.; Burakova, I.V.; Kucherova, A.E.; Agarwal, S.; Tkachev, A.G.; Gupta, V.K. Adsorption of Heavy Metals on Conventional and Nanostructured Materials for Wastewater Treatment Purposes: A Review. Ecotoxicol. Environ. Saf. 2018, 148, 702–712. [Google Scholar] [CrossRef]
- Naik, C.C.; Gaonkar, S.K.; Furtado, I.; Salker, A.V. Effect of Cu2+ Substitution on Structural, Magnetic and Dielectric Properties of Cobalt Ferrite with Its Enhanced Antimicrobial Property. J. Mater. Sci. Mater. Electron. 2018, 29, 14746–14761. [Google Scholar] [CrossRef]
- Abou Hammad, A.B.; Abd El-Aziz, M.E.; Hasanin, M.S.; Kamel, S. A Novel Electromagnetic Biodegradable Nanocomposite Based on Cellulose, Polyaniline, and Cobalt Ferrite Nanoparticles. Carbohydr. Polym. 2019, 216, 54–62. [Google Scholar] [CrossRef]
- Vitta, Y.; Figueroa, M.; Calderon, M.; Ciangherotti, C. Synthesis of Iron Nanoparticles from Aqueous Extract of Eucalyptus Robusta Sm and Evaluation of Antioxidant and Antimicrobial Activity. Mater. Sci. Energy Technol. 2020, 3, 97–103. [Google Scholar] [CrossRef]
- Ramanavičius, S.; Žalnėravičius, R.; Niaura, G.; Drabavičius, A.; Jagminas, A. Shell-Dependent Antimicrobial Efficiency of Cobalt Ferrite Nanoparticles. Nano-Struct. Nano-Objects 2018, 15, 40–47. [Google Scholar] [CrossRef]
- Rajak, R.C.; Saha, P.; Singhvi, M.; Kwak, D.; Kim, D.; Lee, H.; Deshmukh, A.R.; Bu, Y.; Kim, B.S. An eco-friendly biomass pretreatment strategy utilizing reusable enzyme mimicking nanoparticles for lignin depolymerization and biofuel production. Green Chem. 2021, 23, 5584–5599. [Google Scholar] [CrossRef]

| Microorganisms/Sample | Antimicrobial Activity (Zone of Inhibition (dia. in mm)) | |
|---|---|---|
| 50 µL | 100 µL | |
| E. coli | 11 | 16.5 |
| S. aureus | 13.5 | 19 |
Disclaimer/Publisher’s Note: The statements, opinions and data contained in all publications are solely those of the individual author(s) and contributor(s) and not of MDPI and/or the editor(s). MDPI and/or the editor(s) disclaim responsibility for any injury to people or property resulting from any ideas, methods, instructions or products referred to in the content. |
© 2024 by the authors. Licensee MDPI, Basel, Switzerland. This article is an open access article distributed under the terms and conditions of the Creative Commons Attribution (CC BY) license (https://creativecommons.org/licenses/by/4.0/).
Share and Cite
Koul, S.; Singhvi, M.; Kim, B.S. Green Synthesis of Cobalt-Doped CeFe2O5 Nanocomposites Using Waste Gossypium arboreum L. Stalks and Their Application in the Removal of Toxic Water Pollutants. Nanomaterials 2024, 14, 1339. https://doi.org/10.3390/nano14161339
Koul S, Singhvi M, Kim BS. Green Synthesis of Cobalt-Doped CeFe2O5 Nanocomposites Using Waste Gossypium arboreum L. Stalks and Their Application in the Removal of Toxic Water Pollutants. Nanomaterials. 2024; 14(16):1339. https://doi.org/10.3390/nano14161339
Chicago/Turabian StyleKoul, Saloni, Mamata Singhvi, and Beom Soo Kim. 2024. "Green Synthesis of Cobalt-Doped CeFe2O5 Nanocomposites Using Waste Gossypium arboreum L. Stalks and Their Application in the Removal of Toxic Water Pollutants" Nanomaterials 14, no. 16: 1339. https://doi.org/10.3390/nano14161339
APA StyleKoul, S., Singhvi, M., & Kim, B. S. (2024). Green Synthesis of Cobalt-Doped CeFe2O5 Nanocomposites Using Waste Gossypium arboreum L. Stalks and Their Application in the Removal of Toxic Water Pollutants. Nanomaterials, 14(16), 1339. https://doi.org/10.3390/nano14161339

